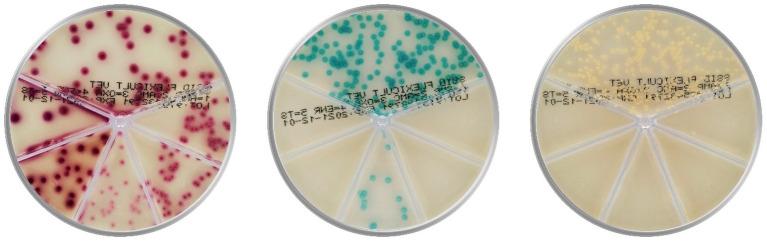

显色培养基在犬猫致病性皮肤细菌的视觉鉴定中辅助诊断细胞学。
Chromogenic culture media complements diagnostic cytology in the visual identification of pathogenic skin bacteria in dogs and cats.
作者信息
Avberšek Miha, Ihssen Julian, Faccio Greta, Spitz Urs, Cugmas Blaž
机构信息
Veterinary Clinic Zamba, Vets4science d.o.o., Celje, Slovenia.
Biosynth AG, Staad, Switzerland.
出版信息
Front Vet Sci. 2023 Jul 11;10:1152229. doi: 10.3389/fvets.2023.1152229. eCollection 2023.
In dogs and cats, bacterial skin infections (pyoderma and otitis externa) are a common cause for visiting the veterinary clinic. The most frequent skin pathogens are , , , and , often requiring different therapeutic antibiotic protocols. Unfavorably, existing diagnostics based on cytology cannot reveal bacterial species but only bacterial shapes such as cocci or rods. This microscopic limitation could be overcome by clinical translation of affordable chromogenic media, which enable species identification based on bacterial colonies growing in different colors and sizes. In this study, we determined how well inexperienced general veterinary clinicians identified bacterial pathogens from the skin and ears on two commercial (Chromatic™ MH and Flexicult® Vet) and one custom-made Mueller Hinton agar-based chromogenic medium. For this purpose, four veterinarians evaluated 100 unique samples representing 10 bacterial species. On average, clinicians correctly identified between 72.1 and 86.3% of bacterial species. Colony colors developed quickly on the Chromatic™ MH medium, leading to the highest 81.6% identification accuracy after 24 h incubation. However, Flexicult® Vet exhibited the highest accuracy of 86.3% after prolonged 48 h incubation. Evaluators easily recognized bacteria displaying uniquely colored colonies like green-brown , blue , orange-brown spp., and red . Oppositely, staphylococci shared uncharacteristically pale pink colonies causing misidentifications among the genus, deteriorating overall accuracy by around 10 percentage points (from 90.9%). Another reason for identification errors was the evaluators' inexperience, reflected in not recognizing colony size differences. For example, although exhibited the tiniest colonies, the species was frequently mistaken for other cocci. Finally, around 10% of errors were negligence-related slips due to unconsidered sample history. To conclude, the introduction of chromogenic media into veterinary clinics can significantly complement diagnostics in skin inflammations by identifying pathogen species in around 80% of cases. The extra information may help in therapeutic dilemmas on antibiotics and standard antimicrobial susceptibility testing. Additional personnel training and evaluation help by visuals, flowcharts, checklists, and, if necessary, microbiologists could further improve identification accuracy.
在犬猫中,细菌性皮肤感染(脓皮病和外耳炎)是前往兽医诊所就诊的常见原因。最常见的皮肤病原体是金黄色葡萄球菌、中间葡萄球菌、伪中间葡萄球菌和奇异变形杆菌,通常需要不同的治疗性抗生素方案。不利的是,现有的基于细胞学的诊断方法无法揭示细菌种类,只能显示细菌形态,如球菌或杆菌。通过将价格实惠的显色培养基进行临床转化可以克服这一微观局限性,这种培养基能够根据不同颜色和大小生长的细菌菌落进行菌种鉴定。在本研究中,我们确定了经验不足的普通兽医临床医生在两种商用(Chromatic™ MH和Flexicult® Vet)以及一种定制的基于穆勒-欣顿琼脂的显色培养基上,从皮肤和耳朵中鉴定细菌病原体的能力如何。为此,四名兽医评估了代表10种细菌的100个独特样本。平均而言,临床医生正确鉴定出72.1%至86.3%的细菌种类。在Chromatic™ MH培养基上,菌落颜色很快就会显现,在培养24小时后,鉴定准确率最高,达到81.6%。然而,Flexicult® Vet在延长培养48小时后,显示出最高的86.3%的准确率。评估人员很容易识别出呈现独特颜色菌落的细菌,如绿棕色的中间葡萄球菌、蓝色的伪中间葡萄球菌、橙棕色的奇异变形杆菌属细菌以及红色的金黄色葡萄球菌。相反,葡萄球菌共有异常淡粉色的菌落,导致该属内出现错误鉴定,使总体准确率降低了约10个百分点(从90.9%)。鉴定错误的另一个原因是评估人员缺乏经验,表现为没有识别出菌落大小的差异。例如,尽管中间葡萄球菌呈现出最小的菌落,但该菌种经常被误认为是其他球菌。最后,约10%的错误是由于疏忽导致的失误,原因是没有考虑样本病史。总之,将显色培养基引入兽医诊所可以通过在约80%的病例中鉴定病原体种类,显著补充皮肤炎症的诊断。这些额外信息可能有助于解决抗生素治疗困境和标准抗菌药敏试验。通过视觉资料、流程图、检查表进行额外的人员培训和评估,如有必要,还可借助微生物学家的帮助,能够进一步提高鉴定准确率。